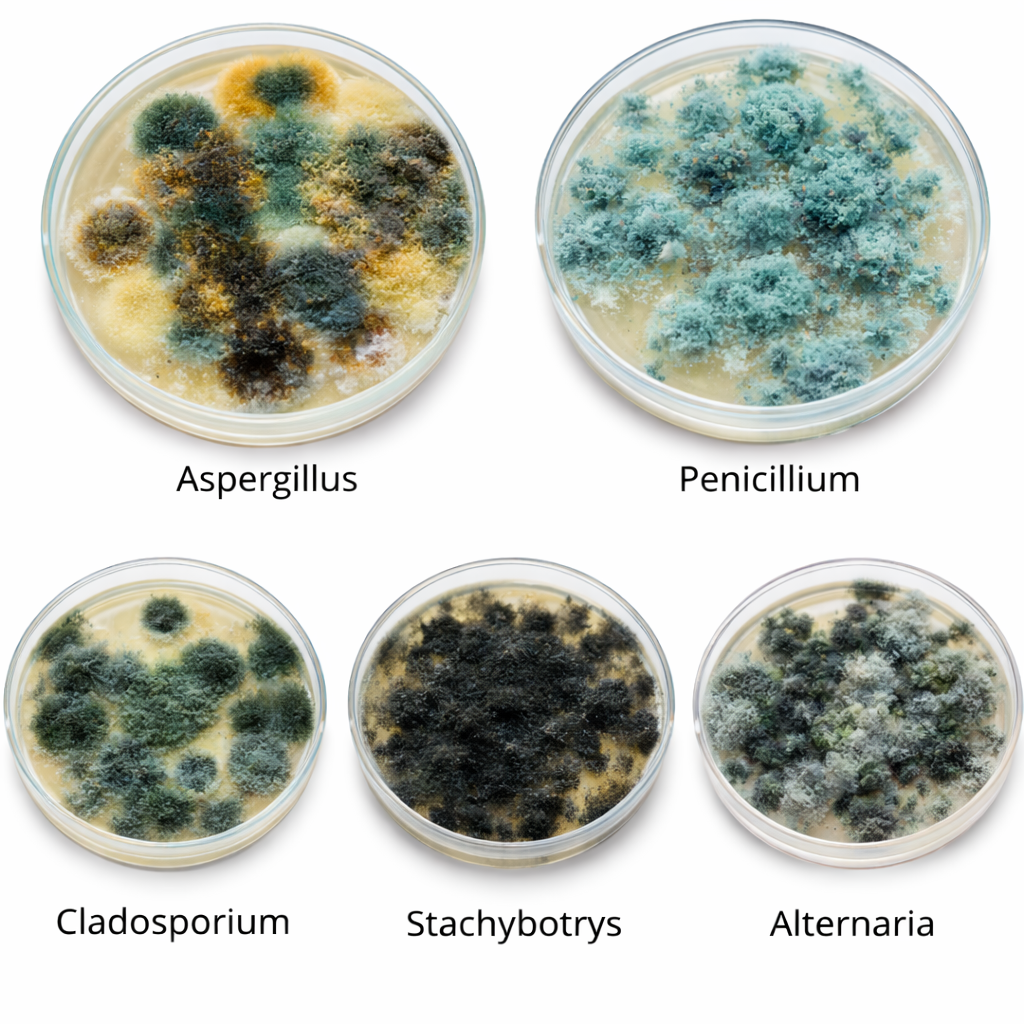
Plísně v českých domácnostech

Údržba fasády není totéž co umytí fasády Nalijme si čistého vína: fasáda není navržená na opakované mytí tlakovou vodou. Obvodový plášť domu není pov...
Blog
Výpis článků
Plísně v českých domácnostech: Jak je rozpoznat a účinně s nimi bojovat Plísně patří mezi nejčastější problémy v českých domácnostech. Objevují se hl...
Tenkovrstvá izolace AERO-THERM® AERO-THERM® je materiál ve formě stěrky, který na povrchu vytváří termoizolační vrstvu. Lze jej aplikovat na různé po...
Fotokatalytické ošetření dřeva představuje inovativní technologii, která může výrazně zlepšit jeho užitné vlastnosti a životnost. Tento článek se zamě...
Samsonova kašna odolává řasám: když věda chrání památky Jak ubránit jednu z nejexponovanějších památek před letním náporem řas a sinic? Odpovědí je t...
Insolace & albedo Slunce je hlavním zdrojem energie pro naši planetu a dvě klíčové veličiny nám pomáhají porozumět, co se s touto energií děje – ...
Česká MedTech start-upová společnost H2 Global Group® představuje funkční prototyp prvního zdravotnického přístroje svého druhu, který je určený k&nbs...
Barva hydroizolace střechy – klíč k teplotné pohodě domu Výběr barvy hydroizolace střechy zásadně ovlivňuje, jaké teploty budou panovat uvnitř domu i...
Samsonova kašna, umístěná na hlavním náměstí Přemysla Otakara II. v Českých Budějovicích, je nejen architektonickou dominantou města, ale také největš...
Co by měl investor vědět o kvalitě vnitřního vzduchu, VOC a dalších parametrech kvality vzduchu…. Vzduch to je komodita, bez které přežijeme jen minu...

.png)